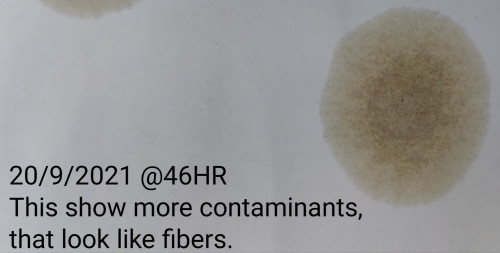
user posted image
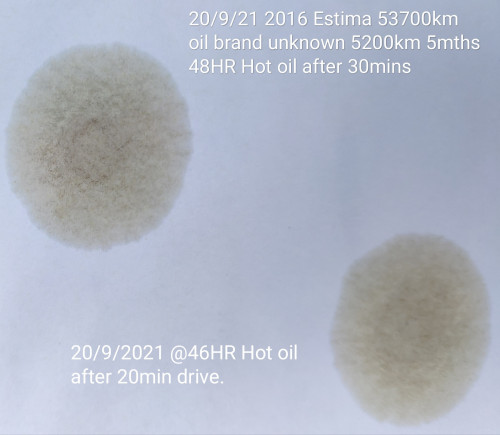
user posted image
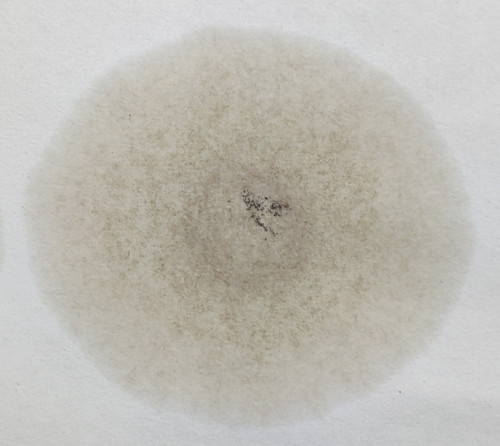
user posted image

QUOTE(incredibless @ Sep 5 2021, 11:06 AM)
Hi bro zeng, with regards to the new updated specs of HX8 i tried to find about the oil whether is it mid saps or high saps. Seems like no info on this. While Petronas Syntium does stated clearly is mid saps. In between both which is more suitable for Direct injection? Typical driving is city drive and occasionally highway drive only.
Shell HX8 w/wo X MB229.5 is a high SaPS oil.European OEMs like VW/Audi do recommend a high SaPS VW 50200 oil for their Direct Injection engines. However, I am not certain whether the same applies to MB.
May be someone knowledgeable on this can help throw some light on MB practice.
I wouldn't be surprised if MB recommends high SaPS oil in their Direct Injection engines, just my speculation.
On Direct Injection engines and SaPS content I do buy the idea that a Mid or Low SaPS oil is preferred to a high SaPS in a DI, though VW/Audi seems to deviate from this at times.....
In your general context, if the fully synthetic oci is say 14,000 kms and less I would likely pick a Petronas C3 to directly benefit (hopefully) from its 'friendlier' relations with DI engines.
If one is adopting say, 16000 kms or more oci I would likely pick any MB 229.5 high SaPS over a Petronas C3 for its assured performance in extended change interval.
So, at the end of the day... there is no right or wrong oil really especially if (typical Asian) car OEM specifies SN/SM only.
Thrust, I still owe you the MB 229.5 thing yeah..
Edit: Approved Mid/Low SaPS oils for MB engines are MB229.51, 229.52 and 226.51 approved.
This post has been edited by zeng: Sep 6 2021, 11:22 AM
Sep 6 2021, 11:15 AM

Quote

0.0338sec
0.56
6 queries
GZIP Disabled